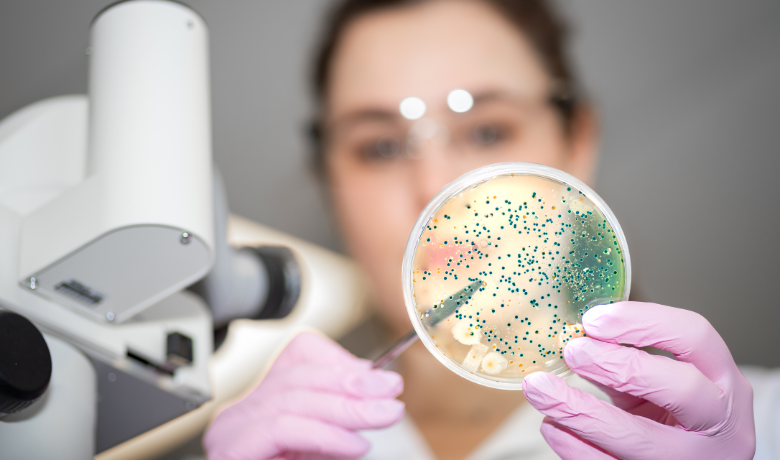

Sintered stainless steel filters, with high strength, durability, and resistance to corrosion,
play a crucial role in numerous industrial processes. Their ability to withstand extreme
temperatures and pressures makes them indispensable in environments demanding precision
and reliability. Here, we explore the top 30 applications where these filters shine, underscoring
their importance across a broad spectrum of industries.
1. Chemical Processing
Sintered stainless steel filters are a workhorse in the chemical processing industry, playing a vital role in ensuring the purity and quality of final products. Here's a deeper dive into their applications in chemical filtration:
* Removing Catalyst Fines:
In chemical reactions, catalysts are often used to accelerate the process. However, these catalysts can shed fine particles during operation. Sintered stainless steel filters effectively remove these catalyst fines from the product stream, preventing them from contaminating the final product or interfering with downstream processes.
* Precursor and Product Filtration:
Chemical reactions often involve the formation of unwanted solids or precipitates during various stages. Sintered stainless steel filters can be used at different points in the process to remove these precursors or isolate the desired product from the reaction mixture. This ensures a cleaner product with improved yield and quality.
* Acid and Solvent Filtration:
Many chemical processes involve harsh environments with strong acids, bases, and solvents. Sintered stainless steel filters, with their excellent corrosion resistance, are well-suited for these applications. They can remove particles like spent activated carbon or filter media used in cleaning processes without being degraded by the chemicals.
* Gas-Liquid Separation:
Chemical reactions often involve gas-liquid mixtures. Sintered stainless steel filters can be used to separate these phases. The filter allows the desired liquid product to pass through while capturing gas bubbles or entrained liquid droplets. This ensures a purer liquid product and prevents foaming issues in downstream equipment.

The specific micron rating of the filter chosen will depend on the size of particles needing removal and the desired level of filtration. Sintered stainless steel filters offer a wide range of micron ratings, making them adaptable to various chemical processing needs. They are also easy to clean and regenerate, ensuring long service life and cost-effectiveness in these demanding environments.
2. Petrochemical Industry
Sintered stainless steel filters play a critical role in oil refining, a complex process that transforms crude oil into a variety of valuable products like gasoline, diesel, and petrochemicals. Here's a closer look at how these filters contribute to cleaner and higher-quality products:
* Desalting:
Crude oil naturally contains brine (saltwater). Sintered stainless steel filters are used in the desalting stage to remove this brine before further processing. This prevents corrosion in downstream equipment and ensures the quality of products derived from the desalted oil.
* Catalyst Recovery:
Catalysts are used in various cracking and reforming processes within refineries to enhance product yield and quality. Sintered stainless steel filters help recover these valuable catalysts from the process stream. Their high strength allows them to withstand the pressure involved in separating catalyst particles from the oil product.
* Contaminant Removal:
Throughout the refining process, various contaminants like catalyst fines, asphaltene particles, and rust can be present in the oil stream. Sintered stainless steel filters, with their appropriate micron rating, effectively remove these contaminants, ensuring cleaner intermediate and final products. This improves product stability, storage life, and performance in end-use applications.
* Hydrotreating:
Hydrotreating processes remove sulfur and other impurities from refined products like gasoline and diesel. Sintered stainless steel filters can be used in these processes to remove spent catalyst and other particulates that could deactivate the fresh catalyst used in the reaction.

The ability of sintered stainless steel filters to withstand high temperatures and pressures makes them ideal for the demanding environment of oil refineries. Additionally, their resistance to corrosion from various hydrocarbons in crude oil ensures long-lasting performance. By removing contaminants and aiding in catalyst recovery, these filters contribute significantly to efficient and high-quality oil refining operations.
3. Gas Processing
Sintered stainless steel filters are a crucial component in ensuring the safe and efficient transportation and utilization of natural gas. Here's a breakdown of their role in natural gas filtration:
* Removing Dust, Dirt, and Liquids:
Natural gas extracted from wells can contain various contaminants like dust, dirt, and liquids. These contaminants can cause problems downstream, such as:
*Abrasion and damage to pipelines and equipment.
*Interfering with the operation of metering and control devices.
*Formation of hydrates (ice crystals) that can block pipelines and disrupt gas flow.
Sintered stainless steel filters, with their appropriate micron rating, effectively remove these contaminants from the natural gas stream. This helps protect pipelines and equipment, ensures accurate flow measurement, and prevents hydrate formation.

* Protecting Compressors and Turbines:
Natural gas often undergoes compression before transportation. Sintered stainless steel filters are used upstream of compressors and turbines to remove any harmful particulates that could cause erosion, damage blades, and reduce efficiency. This extends the lifespan of these critical components and ensures smooth operation of the gas processing facility.
* Filtration for Liquefied Natural Gas (LNG):
For transport over long distances, natural gas is often liquefied (LNG). Sintered stainless steel filters play a role in pre-cooling and liquefaction processes by removing contaminants that could solidify and block pipelines or interfere with heat transfer during LNG production.
The high strength and durability of sintered stainless steel filters make them suitable for the high-pressure environment of natural gas processing. They can also withstand the cryogenic temperatures encountered in LNG production. Their ability to be cleaned and reused further adds to their cost-effectiveness in this industry. By ensuring clean and contaminant-free natural gas, these filters contribute to reliable and efficient gas processing operations.

4. Pharmaceutical Manufacturing
Sintered stainless steel filters are vital for ensuring sterility and purity in pharmaceutical manufacturing. Here's a more detailed look at their role in sterile processing:
* Microbial Removal:
Pharmaceutical products must be free from microorganisms like bacteria, viruses, and fungi to prevent contamination and ensure patient safety. Sintered stainless steel filters with a specific micron rating, typically in the 0.1 to 0.2 micrometer range, act as a physical barrier to remove these microbes from liquids, gases, and even air streams used in pharmaceutical manufacturing.
* Pre-filtration and Final Filtration:
Sintered stainless steel filters can be employed at various stages of pharmaceutical production. They might be used for pre-filtration to remove larger particles before more critical steps or for final sterilization filtration to ensure the complete absence of microbes in the final product.
* Venting and Gas Filtration:
Maintaining a sterile environment is crucial in pharmaceutical manufacturing. Sintered stainless steel filters are used for sterile venting of tanks and equipment, removing contaminants from gases used in manufacturing processes, and filtering compressed air used to operate various machinery.
* Benefits for Aseptic Processing:
Aseptic processing involves filling sterile products into sterile containers in a controlled environment. Sintered stainless steel filters play a vital role in this process by ensuring the sterility of gases and liquids used during filling and by maintaining a clean air environment within the filling zone.

The key advantage of sintered stainless steel filters in this application is their ability to be sterilized themselves. They can withstand high temperatures and harsh chemicals used in sterilization processes like steam autoclaving or chemical disinfection. This reusability makes them cost-effective and reduces waste generation compared to disposable filters.
By ensuring sterility throughout the manufacturing process, sintered stainless steel filters contribute significantly to the production of safe and effective pharmaceutical products.
5. Food and Beverage Industry
Sintered stainless steel filters play a vital role in ensuring the clarity, purity, and safety of various liquid food products in the food and beverage industry. Let's delve deeper into their specific applications:
* Clarification:
Many liquid food products, like juices, syrups, and some wines, benefit from clarification to remove unwanted particles and achieve a clear, appealing appearance. Sintered stainless steel filters with appropriate micron ratings can effectively remove these particles, such as pulp, yeast, or sediment, without altering the taste or aroma of the product.
* Pre-filtration for Sterilization:
Sintered stainless steel filters can be used as a pre-filtration step before processes like pasteurization or sterile filtration. By removing larger particles and contaminants, they protect the integrity of downstream sterilization membranes and extend their lifespan. This translates to cost savings and improved efficiency in the production line.
* Microfiltration:
For some beverages like beer or wine, microfiltration with sintered stainless steel filters can be used to remove specific microorganisms while allowing desired flavor components to pass through. This technique helps achieve product stability and extend shelf life without compromising the taste profile.
* Safety and Hygiene:
Sintered stainless steel filters are known for their excellent resistance to corrosion and ease of cleaning. This makes them ideal for the hygienic food and beverage production environment. They can be used to filter water used in various stages of production, ensuring its purity and preventing contamination of final products.
* Versatility for Different Products:
The ability to customize the micron rating of sintered stainless steel filters allows them to be used for a wide range of liquid food products. From coarse filtration of syrups to fine filtration of wine, these filters offer a versatile solution for various clarification and purification needs.

The high durability of sintered stainless steel filters ensures they can withstand the rigors of food and beverage production environments. They are also compatible with cleaning processes using food-grade sanitizers and can be reused multiple times, making them a cost-effective and sustainable filtration solution for the industry. By contributing to the clarity, purity, and safety of liquid food products, sintered stainless steel filters play a significant role in delivering high-quality beverages to consumers.
6. Water Treatment
Sintered stainless steel filters are a workhorse in desalination plants, particularly during the pre-filtration stage. Here's a closer look at their role in this application:
* Protecting Reverse Osmosis Membranes:
The heart of many desalination systems is the reverse osmosis (RO) membrane. This thin membrane allows water molecules to pass through while rejecting dissolved salts and other impurities. However, RO membranes are susceptible to damage from particulates like sand, silt, and algae.
Sintered stainless steel filters, with appropriate micron rating, act as a pre-filter upstream of the RO membranes. They effectively remove these particulates from the seawater feed, protecting the delicate membranes and extending their lifespan. This translates to significant cost savings, as RO membranes can be expensive to replace.

* Extending Maintenance Intervals:
By preventing particulates from reaching the RO membranes, sintered stainless steel filters reduce membrane fouling. This reduces the frequency of cleaning cycles required for the membranes, leading to less downtime and improved efficiency of the desalination plant.
* Consistent Performance:
Sintered stainless steel filters offer consistent and reliable filtration performance. They are resistant to corrosion from seawater and can withstand the high pressures encountered in desalination processes. This ensures a steady supply of pre-filtered water for the RO membranes, contributing to the overall stable operation of the desalination plant.
* Multiple Filtration Stages:
In some desalination plants, sintered stainless steel filters might be used in multiple stages of pre-filtration. Initially, a filter with a larger micron rating might be used to remove larger debris, followed by a finer filter to capture even smaller particulates before the RO membranes.
Overall, sintered stainless steel filters play a critical role in desalination by safeguarding the integrity and performance of RO membranes. This allows desalination plants to produce clean freshwater from seawater in a cost-effective and efficient manner.
7. Aerospace and Defense
Sintered stainless steel filters are undeniably crucial in ensuring the smooth operation and safety of hydraulic systems in aerospace and defense applications. Here's a breakdown of their critical role:

* Preserving System Performance:
Hydraulic systems power various critical functions in aircraft, missiles, and military vehicles. Contamination in these systems, even at minute levels, can lead to component wear, malfunction, and potential system failure. Sintered stainless steel filters, with their precise micron rating, effectively remove wear debris, dirt, and other contaminants from the hydraulic fluid. This maintains system cleanliness, minimizes friction and wear, and ensures optimal performance of hydraulic components.
* Protecting High-Precision Components:
Aerospace and defense hydraulic systems often contain sophisticated valves, actuators, and other precision components. Sintered stainless steel filters safeguard these components from damage by capturing particles that could cause abrasions or interfere with their operation. This extends the lifespan of these critical components and reduces maintenance requirements.
* Reliability in Harsh Environments:
Aircraft and military vehicles operate in diverse and demanding environments, experiencing extreme temperatures, high pressures, and vibrations. Sintered stainless steel filters are built to withstand these harsh conditions. They offer excellent resistance to corrosion and maintain their structural integrity, ensuring reliable filtration performance throughout the system's operation.

* Fuel System Filtration:
Beyond hydraulic systems, sintered stainless steel filters can also be used in fuel systems for aircraft and military vehicles. They remove contaminants from jet fuel or diesel, protecting engines from wear and ensuring smooth operation.
* Material Compatibility:
Sintered stainless steel filters are available in various grades to ensure compatibility with different types of hydraulic fluids used in aerospace and defense applications. This ensures optimal filtration performance without compromising the integrity of the filter media or the surrounding system.
The ability of sintered stainless steel filters to be cleaned and reused in some cases makes them a cost-effective solution for these demanding applications. By maintaining the cleanliness and integrity of hydraulic and fuel systems, these filters play a vital role in ensuring the reliability, safety, and successful operation of aerospace and defense vehicles.
8. Automotive Industry
Fuel Filtration: Enhancing the performance and lifespan of automotive engines by ensuring clean fuel supply.
Sintered stainless steel filters are a key player in keeping modern automobiles running smoothly and efficiently. Here's a deeper dive into their role in fuel filtration:
* Protecting Engine Components:
Modern fuel injection systems rely on precise tolerances to ensure optimal engine performance and fuel economy. Contaminants like dirt, rust, and scale present in gasoline or diesel fuel can damage injectors, pumps, and other engine components. Sintered stainless steel filters, with their appropriate micron rating, effectively remove these contaminants before they reach the engine. This protects critical components from wear and tear, extending engine life and maintaining optimal performance.
* Preventing Injector Clogging:
Fuel injectors are precision components with tiny nozzles that deliver a fine spray of fuel into the engine cylinders. Even small particles can clog these injectors, leading to rough idling, power loss, and increased emissions. Sintered stainless steel filters capture these contaminants before they reach the injectors, ensuring a consistent and clean fuel supply for optimal combustion.

* Compatibility with Biofuels:
The increasing use of biofuels like biodiesel blends in automotive applications presents new challenges for fuel filtration. Sintered stainless steel filters are often chosen for their compatibility with these biofuels. They can withstand the corrosive nature of some biofuels while maintaining effective filtration performance.
* High Durability and Reliability:
The automotive environment can be harsh, with constant vibrations and temperature fluctuations. Sintered stainless steel filters offer exceptional durability and can withstand these demanding conditions. They are built to last for the lifespan of the vehicle, ensuring consistent and reliable filtration throughout.
* Washable and Reusable (in some cases):
Some sintered stainless steel fuel filters can be cleaned and reused, making them a more sustainable and cost-effective option compared to disposable filters. This reusability, however, depends on the specific design and manufacturer's recommendations.
By ensuring a clean and contaminant-free fuel supply, sintered stainless steel filters contribute significantly to the smooth operation, longevity, and performance of modern automotive engines. They play a crucial role in maintaining fuel efficiency, reducing emissions, and providing a reliable driving experience.
9. Power Generation
Sintered stainless steel filters are a workhorse in power plants, playing a critical role in cooling water filtration systems. Here's a closer look at how they contribute to efficient and reliable power generation:
* Protecting Heat Exchangers:
In power plants, cooling water is used to absorb heat from various components like turbines, condensers, and generators. This heat exchange process is essential for maintaining optimal operating temperatures and preventing equipment damage. Sintered stainless steel filters are placed strategically within the cooling water system to remove contaminants like:* Sand, silt, and other debris that can clog heat exchanger tubes and reduce heat transfer efficiency.
* Algae, mussels, and other biological organisms that can grow in cooling water systems and impede water flow.
By removing these contaminants, sintered stainless steel filters ensure efficient heat exchange, allowing power plants to operate at optimal capacity.
* Preventing Corrosion:
The presence of dissolved oxygen, chlorides, and other minerals in cooling water can lead to corrosion of pipes, heat exchangers, and other equipment within the power plant. Sintered stainless steel filters can help mitigate this risk by removing some corrosive particles and promoting the effectiveness of corrosion inhibitor chemicals added to the cooling water.
* Extending Equipment Life:
Clean cooling water minimizes wear and tear on pumps, valves, and other components within the cooling system. This translates to extended equipment life, reduced maintenance costs, and improved overall plant reliability.
* Material Selection for Specific Needs:
Sintered stainless steel filters come in various grades, offering different levels of corrosion resistance. Power plants can choose the most appropriate grade based on the specific composition of their cooling water and its potential corrosivity.
* Durability in High-Pressure Environments:
Power plant cooling water systems operate under high pressure. Sintered stainless steel filters are known for their exceptional strength and ability to withstand these pressures, ensuring reliable filtration performance.

* Compatibility with Treatment Chemicals:
The cooling water in power plants is often treated with chemicals like biocides and algaecides to control biological growth. Sintered stainless steel filters are generally compatible with these chemicals, allowing for effective filtration while maintaining system integrity.
By maintaining clean cooling water and protecting equipment from corrosion, sintered stainless steel filters play a significant role in ensuring the efficient, reliable, and safe operation of power generation facilities.
10. Biotechnology
Cell Culture Media Filtration: Ensuring the sterility and purity of cell culture media in biotech research and production.
Sintered stainless steel filters are a valuable tool in biotechnology, particularly for cell culture media filtration. Here's a breakdown of their role in ensuring sterility and purity:
* Sterile Filtration:
Cell culture experiments and production processes require sterile media to prevent contamination from bacteria, viruses, and other microorganisms. Sintered stainless steel filters with a specific micron rating, typically in the 0.1 to 0.2 micrometer range, act as a physical barrier to remove these contaminants from cell culture media.
* Benefits over Disposable Filters:
While disposable filters are commonly used in cell culture, sintered stainless steel filters offer some advantages:
* Cost-effectiveness:
Sintered stainless steel filters can be cleaned and reused multiple times, reducing the ongoing cost of filtration compared to disposable filters.
* Sustainability:
Reusability translates to less waste generation compared to disposable filters.
* High Flow Rates:
Sintered stainless steel filters can often handle higher flow rates than disposable filters, which can be beneficial for large-scale cell culture applications.
* Pre-filtration:
In some cases, sintered stainless steel filters might be used for pre-filtration of cell culture media before sterile filtration. This pre-filtration step can remove larger particles like cell debris or media components, protecting the integrity of the final sterile filtration membrane.
* Maintaining Media Integrity:
Cell culture media contains various nutrients and growth factors essential for cell health. Sintered stainless steel filters are designed to be minimally interactive with the media, minimizing the risk of adsorption or leaching of these vital components.
* Compatibility with Cleaning and Sterilization Techniques:
Sintered stainless steel filters can withstand the high temperatures and harsh chemicals used in cleaning and sterilization processes like steam autoclaving or chemical disinfection. This reusability makes them a practical and cost-effective option for cell culture applications.

By ensuring the sterility and purity of cell culture media, sintered stainless steel filters contribute significantly to successful cell culture experiments and production processes in the field of biotechnology. They offer a balance of performance, reusability, and cost-effectiveness compared to traditional disposable filtration methods.
11. Semiconductor Manufacturing
Sintered stainless steel filters play a vital role in the heart of modern technology – semiconductor manufacturing. Here's a detailed look at their critical function in process gas filtration:
* Maintaining Ultra-Clean Environments:
Semiconductor devices are incredibly miniaturized, requiring an environment with near-perfect cleanliness. Even the tiniest particle contamination can disrupt the delicate fabrication processes and render chips unusable. Sintered stainless steel filters act as a final line of defense, removing particulates down to incredibly small sizes (often 0.08 micrometers or less) from the ultra-clean gases used in various stages of chip production.
* Protecting Expensive Equipment:
Semiconductor fabrication equipment is highly sophisticated and expensive. Contamination from particles in the process gases can damage these tools, leading to costly downtime and production delays. Sintered stainless steel filters ensure clean gases reach the equipment, minimizing the risk of contamination and extending equipment lifespan.
* High Purity and Consistency:
The performance and reliability of modern semiconductors depend on the purity and consistency of the materials used during fabrication. Sintered stainless steel filters offer consistent and reliable filtration performance, ensuring a steady supply of ultra-clean process gases throughout the manufacturing process.
* Compatibility with Diverse Gases:
Semiconductor manufacturing utilizes a wide range of gases like nitrogen, oxygen, argon, and various dopant gases. Sintered stainless steel filters are compatible with these diverse gases, offering effective filtration without compromising the chemical integrity of the process gas.
Benefits over Traditional Filters:
Compared to traditional membrane filters, sintered stainless steel filters offer several advantages:
1 Durability:
They can withstand the high pressures and temperatures encountered in semiconductor fabrication processes.
2 Regenerability:
Many sintered stainless steel filters can be cleaned and reused, reducing waste and lowering long-term filtration costs.
3 High Flow Rates:
They can handle the high flow rates of process gases required in modern fabs (fabrication facilities).
Material Selection:
Sintered stainless steel filters come in various grades, with some offering ultra-high purity to minimize the risk of outgassing (release of trapped gases) that could contaminate the process environment.
By ensuring the cleanliness and purity of process gases, sintered stainless steel filters are instrumental in the successful and cost-effective production of modern semiconductor chips, the foundation of countless electronic devices we rely on today.
12. Laboratory Research
Air and Gas Sampling: Employed in labs to filter air and gas samples for research and analytical purposes.
Sintered stainless steel filters are a valuable tool in laboratory research, particularly for air and gas sampling applications. Here's a closer look at their contributions:
* Removing Particulates for Analysis:
In various research fields, scientists need to analyze the composition of airborne particles. Sintered stainless steel filters with appropriate micron ratings can effectively capture these particles from air or gas samples. This allows for subsequent analysis of the collected particles using techniques like microscopy or spectroscopy to identify their composition and origin.
* Protecting Sampling Equipment:
Sensitive laboratory instruments used for gas analysis can be damaged by airborne dust or particulate matter. Sintered stainless steel filters placed at the inlet of these instruments act as a barrier, preventing particles from reaching and potentially damaging the delicate components.
* Pre-concentration of Samples:
For trace gas analysis, where the target gas components are present in very low concentrations, sintered stainless steel filters can be used for pre-concentration. The filter can trap the desired gas molecules while allowing other abundant gases to pass through. This concentrated sample can then be analyzed more effectively.
* Sterile Filtration for Biological Samples:
In some research areas, like microbiology or bioanalysis, sterile sampling and filtration are crucial. Sintered stainless steel filters with appropriate micron ratings (typically 0.1 to 0.2 micrometers) can be used for sterile filtration of air or gas samples containing microorganisms. This ensures sterility and prevents contamination in downstream analysis or culturing experiments.
1. Durability and Chemical Compatibility:
Laboratory environments can involve exposure to a variety of chemicals. Sintered stainless steel filters offer good chemical resistance and can withstand cleaning with various solvents, making them suitable for use with diverse research samples.
2. Reusable Option:
Some sintered stainless steel filters designed for laboratory use can be cleaned and reused multiple times. This reusability reduces waste generation compared to disposable filters and can be more cost-effective in the long run.
By enabling the collection, pre-concentration, and sterile filtration of air and gas samples, sintered stainless steel filters play a significant role in supporting various research endeavors across scientific disciplines. Their versatility, durability, and reusability make them a valuable tool for laboratories.
Are you looking for some Sintered Stainless Steel Filter Elements
for your Industry Filtration Parts ?
Then Check some features, you can decide if the Sintered Stainless Steel Filter is the right filter elements
for your project:
Based on the various applications explored, here are some of the main features of Sintered Stainless Steel Filters:

1. High Durability and Strength:
Due to the sintering process, these filters are incredibly strong and resistant to wear and tear. They can withstand demanding environments with high pressures and vibrations
.
2. Excellent Corrosion Resistance:
Sintered stainless steel is known for its resistance to corrosion from various chemicals, liquids, and gases encountered in numerous industries.
3. High Permeability and Filtration Efficiency:
The sintered structure allows for good flow rates while effectively capturing particles down to very small sizes, depending on the micron rating chosen.
4. Temperature Resistance:
These filters can withstand a wide range of temperatures, from extremely low temperatures used in cryogenic applications to high temperatures encountered in processes like oil refining.
5. Sterilizability:
They can be sterilized using high temperatures and harsh chemicals, making them suitable for applications requiring sterile filtration.
6. Reusability:
Many sintered stainless steel filters can be cleaned and reused multiple times, offering a cost-effective and sustainable filtration solution compared to disposable filters.
7. Versatility:
With various micron ratings, material grades, and filter element configurations available, they can be adapted to a wide range of filtration needs across numerous industries.
8. Compatibility:
They are compatible with a diverse range of liquids, gases, and chemicals used in various industrial processes.
Not Sure If Sintered Stainless Steel Filters Are Right For Your Project?
Choosing the right filtration solution requires careful consideration of compatibility, efficiency, and application needs.
If you're unsure whether sintered stainless steel filters are the right fit, welcome you to contact us, we're here to guide you.
Why HENGKO?
*Expertise in Design & Manufacturing: High-quality sintered stainless steel filters tailored to your exact needs.
*Industry Versatility: Solutions for pharmaceutical, food & beverage, chemical processing, and more.
*Custom OEM Solutions: Filters designed for optimal performance in your specific application.
Contact us at ka@hengko.com to discuss your requirements.
Let’s create the perfect filtration solution together!
Send your message to us:
Post time: Mar-22-2024
